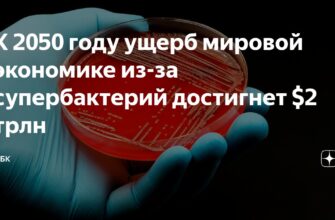

Новости медицины
21 июля, 13:14 | Просмотров: 3525 | Фотогалерея (10)
Устойчивость бактерий к антибиотикам предвещает тяжелейшие
Сильные дожди, прошедшие в Подмосковье, привели к заметной
Екатерининский парк в самом сердце Москвы стал настоящим
20 июля 20 июля отмечает свой 62-й день рождения Александр Жулин.
Агдам, азербайджанский город, чье название стало символом
Принц Саудовской Аравии Аль-Валид бин Халид Аль-Сауд
Здесь будет размещено видео Легендарный футбольный
В Барнауле произошел серьезный инцидент: пожар вспыхнул
Андрей Белоусов, глава оборонного ведомства России